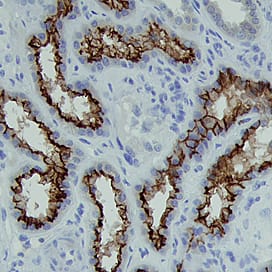
ACE-2 antibody in Human Kidney by Immunohistochemistry (IHC-P).

Human/Hamster ACE-2 Antibody
R&D Systems, part of Bio-Techne | Catalog # MAB933


Key Product Details
Species Reactivity
Validated:
Cited:
Applications
Validated:
Cited:
Label
Antibody Source
Product Specifications
Immunogen
Gln18-Ser740 (predicted)
Accession # Q9BYF1
Specificity
Clonality
Host
Isotype
Scientific Data Images for Human/Hamster ACE-2 Antibody
Detection of Human ACE‑2 by Western Blot.
Western blot shows lysates of NS0 mouse myeloma cell line and human kidney tissue. PVDF membrane was probed with 2 µg/mL of Mouse Anti-Human ACE-2 Monoclonal Antibody (Catalog # MAB933) followed by HRP-conjugated Anti-Mouse IgG Secondary Antibody (Catalog # HAF007). A specific band was detected for ACE-2 at approximately 110 kDa (as indicated). This experiment was conducted under reducing conditions and using Immunoblot Buffer Group 1.ACE‑2 in Human Kidney.
ACE-2 was detected in immersion fixed paraffin-embedded sections of human kidney using Mouse Anti-Human ACE-2 Monoclonal Antibody (Catalog # MAB933) at 15 µg/mL overnight at 4 °C. Before incubation with the primary antibody, tissue was subjected to heat-induced epitope retrieval using Antigen Retrieval Reagent-Basic (Catalog # CTS013). Tissue was stained using the Anti-Mouse HRP-DAB Cell & Tissue Staining Kit (brown; Catalog # CTS002) and counterstained with hematoxylin (blue). Specific staining was localized to cell surface of epithelial cells in convoluted tubules. View our protocol for Chromogenic IHC Staining of Paraffin-embedded Tissue Sections.ACE-2 in Hamster Lung.
ACE-2 was detected in immersion fixed paraffin-embedded sections of hamster lung using Mouse Anti-Human ACE-2 Monoclonal Antibody (Catalog # MAB933) at 10 µg/mL for 1 hour at room temperature followed by incubation with the Anti-Mouse IgG VisUCyte™ HRP Polymer Antibody (VC001). Before incubation with the primary antibody, tissue was subjected to heat-induced epitope retrieval using Antigen Retrieval Reagent-Basic (CTS013). Tissue was stained using DAB (brown) and counterstained with hematoxylin (blue). Specific staining was localized to respiratory bronchioles. Staining was performed our protocol for IHC Staining with VisUCyte HRP Polymer Detection Reagents.Applications for Human/Hamster ACE-2 Antibody
Immunohistochemistry
Sample: Immersion fixed paraffin-embedded sections of human kidney and hamster lung.
Western Blot
Sample: NS0 mouse myeloma cell line and human kidney tissue
Reviewed Applications
Read 4 reviews rated 4.5 using MAB933 in the following applications:
Formulation, Preparation, and Storage
Purification
Reconstitution
Formulation
Shipping
Stability & Storage
- 12 months from date of receipt, -20 to -70 °C as supplied.
- 1 month, 2 to 8 °C under sterile conditions after reconstitution.
- 6 months, -20 to -70 °C under sterile conditions after reconstitution.
Background: ACE-2
Angiogensin I Converting Enzyme-2 (ACE-2), also called ACEH (ACE homolog), is a type I transmembrane zinc protease that cleaves angiotensins I and II to produce vasodilatory and anti-proliferative peptides. The balance between ACE-1 and ACE-2 activity is critical for maintaining cardiovascular, renal, and pulmonary function (1). ACE-2 also functions as the cellular uptake receptor for the SARS coronoavirus. Within the extracellular domain, human ACE-2 shares 83% aa sequence identity with mouse and rat ACE-2. Human ACE-2 has about 40% amino acid identity to the N- and C-terminal domains of human somatic ACE. The predicted human ACE-2 protein sequence consists of 805 amino acids, including a N-terminal signal peptide, a single catalytic domain, a C-terminal membrane anchor, and a short cytoplasmic tail. ACE-2 mRNA is found at high levels in testis, kidney and heart and at moderate levels in colon, small intestine and ovary. Classical ACE inhibitors such as captopril and lisinopril do not inhibit ACE-2 activity. Novel peptide inhibitors of ACE-2 do not inhibit ACE activity (2). Genetic data from Drosophila, mice and rats show that ACE-2 is an essential regulator of heart function in vivo (3). ACE-2 isoforms of 75 kDa and 120 kDa are differentially expressed between lung and kidney, respectively, and a shed soluble form is generated by TACE/ADAM17 mediated cleavage.
References
- Tipnis, S.R. et al. (2000) J. Biol. Chem. 275:33238.
- Crackower, M.A. et al. (2002) Nature 417:822.
- Huang, L. et al. (2003) J. Biol. Chem. 278:15532.
Long Name
Alternate Names
Entrez Gene IDs
Gene Symbol
UniProt
Additional ACE-2 Products
Product Documents for Human/Hamster ACE-2 Antibody
Product Specific Notices for Human/Hamster ACE-2 Antibody
For research use only